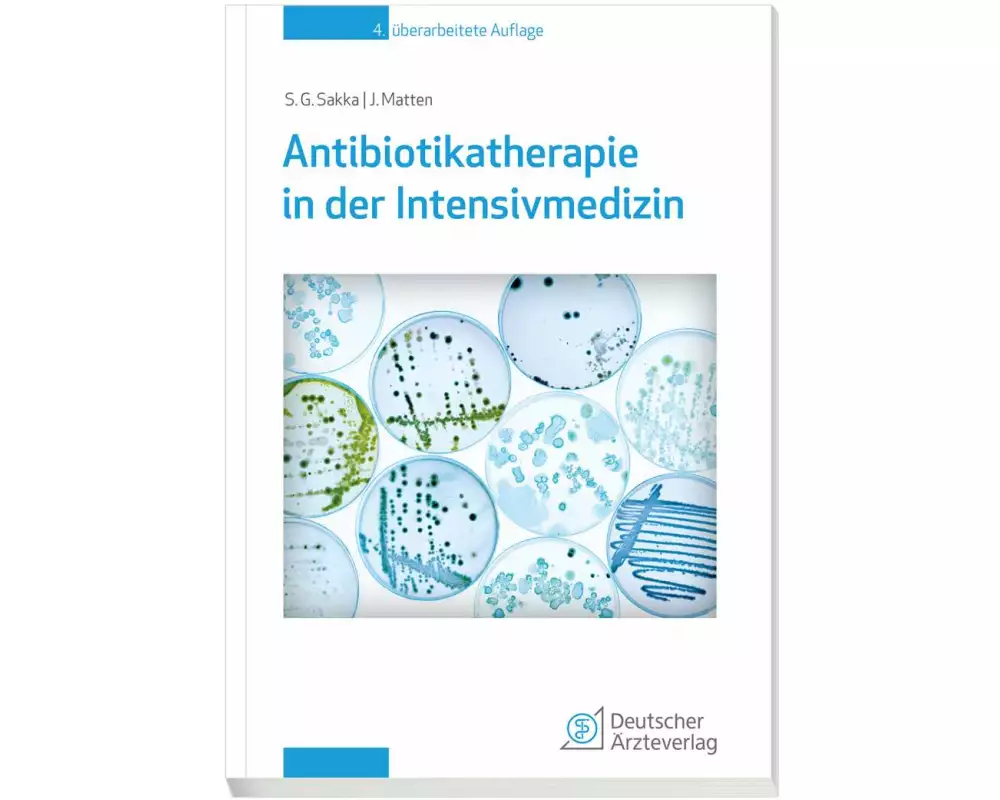
Antibiotikatherapie in der Intensivmedizin

Autor/-in: Jens Matten
Dr. med. Jens Matten ist Facharzt für Mikrobiologie, Virologie und Infektionsepidemiologie
Reisemedizin u. DTM&P und ist als Standortleitung und ärztliche Leitung am
LADR Laborzentrum Nord-West Facharzt für Mikrobiologie, Virologie und Infektionsepidemiologie tätig
Hier finden Sie zu den besten Preisen alle Bücher, eBooks und Hörbücher von Jens Matten.
Bestellungen bis 15:00 Uhr für Produkte auf Lager erhalten Sie - ohne Versandgebühr - am nächsten Werktag.
1
Meistgekauft